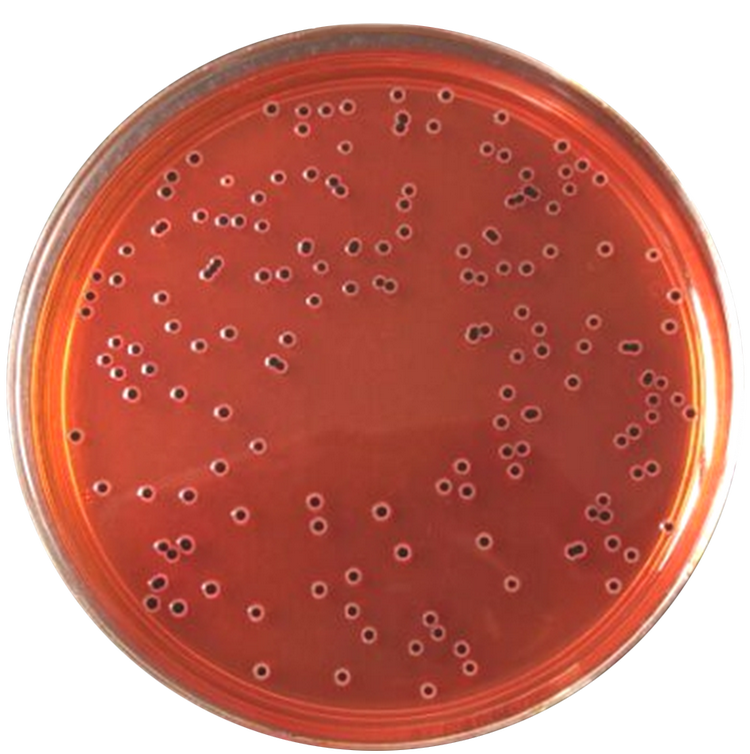
沙门氏菌

历史与命名
1884年美国兽医微生物和病理学家沙门(Daniel Elmer Salmon)和他的同事史密斯(Theobald Smith),从患有“猪霍乱”的猪肠道中分离出来一种微生物,他们认为这种微生物是导致这种疾病的原因,于是他们将其命名为“霍乱芽孢杆菌”。直到1900年,法国细菌学家Liengieres将霍乱芽孢杆菌提升为一个属,并以沙门(Daniel Elmer Salmon)的名字将其命名为“沙门氏菌”。故以后凡属于该菌属的细菌均以沙门(Salmon)命名,如鸭沙门氏菌、猪霍乱沙门氏菌、鼠伤寒沙门氏菌等,各型沙门氏菌病中发病率最高的是鼠伤寒沙门氏菌。1939年Caldwell和Reyerson于在冷血动物中最早发现亚利桑那沙门氏菌。1943年由Wheele和Borman首先发现婴儿沙门氏菌。
分类
沙门氏菌包含肠道沙门菌(S.enterica)和邦戈沙门菌(S.bongori)两个种属,肠道沙门菌又分为6个亚种,即Ⅰ肠道亚种(subsp.enterica)、Ⅱ萨拉姆亚种(subsp.salamae)、Ⅲa亚利桑那亚种(subsp.arizonae)、Ⅲb双亚利桑那亚种(subsp.diarizonae)、Ⅳ豪顿亚种(subsp.houtenae)和Ⅵ英迪加亚种(subsp.indica)。其中伤寒与副伤寒是由肠沙门菌肠亚种伤寒血清型和肠沙门菌肠亚种副伤寒(甲或乙或丙血清型)感染引起的一种肠道传染病,肠沙门菌肠亚种伤寒血清型也常被简称为伤寒沙门菌,肠沙门菌肠亚种副伤寒甲血清型常被称为甲型副伤寒沙门菌。
沙门菌属细菌的血清型现已达2500多种,少数血清型如伤寒沙门菌、甲型副伤寒沙门菌、肖氏沙门菌(原称乙型副伤寒沙门菌)和希氏沙门菌(原称丙型副伤寒沙门菌)是人的病原菌,对人类有直接的致病作用,引起肠热症,对非人类宿主不致病。绝大多数血清型宿主范围广泛,家畜、家禽、野生脊椎动物以及冷血动物、软体动物、环形动物、节肢动物(包括苍蝇)等均可带菌,其中部分沙门菌是人畜共患病的病原菌,可引起人类食物中毒或败血症。动物感染大多无症状或为自限性胃肠炎。
病原学
形态与基因组特征
革兰阴性杆菌,大小(0.6~1.0)μmx(2~4)μm,有菌毛。除鸡沙门菌和雏沙门菌(S.pullorum)等个别例外,都有周身鞭毛,一般无荚膜,均无芽胞。沙门菌基因组大小与大肠埃希菌相近,至少包含7个致病岛(SPI)以及大量前噬菌体,其中SPI-1和SPI-2与Ⅲ型分泌系统有关。

理化特征
不分解乳糖、蔗糖、侧金盏花醇和水杨苷,不产靛基质,不溶化明胶,不分解尿素,不产生乙酰甲基醇,能利用枸橼酸盐,还原硝酸盐,无苯丙氨酸酰氢酶,在氰化钾培养基上不生长。对葡萄糖、麦芽糖和甘露糖发酵,除伤寒沙门菌产酸不产气外,其他沙门菌均产酸产气。沙门菌在克氏双糖管中,斜面不发酵和底层产酸产气(但伤寒沙门菌产酸不产气),硫化氢阳性或阴性,动力阳性。可同大肠埃希菌、志贺菌等区别;在此基础上,利用尿素酶试验可同变形杆菌相区别。
培养特性
沙门氏菌属于需氧或兼性厌氧菌,最适温度为37℃,pH为6.8~7.8,营养要求不高,在普通琼脂平板上可生长,在SS选择鉴别培养基上形成中等大小、无色、半透明的S型菌落。沙门氏菌在水中活2~3周,粪便生存1~2月,在水中冻土地可生存半年,加热60℃15分钟即死亡,5%石灰酸5分钟可杀死。
抗原构造
沙门氏菌抗原构造分为菌体抗原(O)、鞭毛抗原(H)和表面抗原(Vi)三种,分型根据抗原构造,参考生化反应,如根据O抗原分型,伤寒杆菌在D群含O抗原9,12和Vi;甲型副伤寒为A群含O抗原1,2,12;乙型副伤寒为B群,含O抗原6,7和Vi。沙门氏菌属可发生自发性突变,其中有S-R变异其结果为O抗原消失。H-O变异失去H抗原。V-W变异Vi抗原消失,这三种变异较稳定,其他还有相位变异是可逆的。
致病性
沙门氏菌有较强的内毒素,并有一定的侵袭力,个别菌型尚能产生肠毒素。
免疫性
肠热症后可获得一定程度的免疫性。恢复后2~3周复发的情况存在,但比首次感染要轻得多。沙门氏菌侵入宿主之后,主要在细菌内生长繁殖,要彻底杀灭这类胞内寄生菌,特异性细胞免疫是主要防御机制。在致病过程中,沙门氏菌亦可有存在于血流和细胞外的阶段,故特异性体液抗体也有辅助杀菌作用。胃肠炎的恢复与肠道局部生成slgA有关。
耐药性
药物外排作用
药物外排作用是细菌中普遍存在的一种重要耐药机制,由药物外排泵所介导,可为细菌提供多重耐药功能,对于细菌的生存至关重要。药物外排泵是一类位于细胞膜上的特殊膜转运蛋白,当细胞内药物浓度达到某一临界值时,可激活调节基因增强药物外排泵系统组分蛋白的表达量,使得细菌细胞膜的外排能力增强,从而将细胞内的药物排出。药物外输系统引起的耐药性无药物特异性,但外排系统所作用的药物种类存在一定的差异。目前已证实了沙门菌存在包括AcrAB、macAB等9种外排泵系统,它们的活动性与细菌的耐药水平均存在一定相关性。
改变细胞膜的通透性
沙门菌可通过降低菌体外膜上的某些膜孔蛋白的表达量,使细胞菌对抗生素的通透性下降。该耐药机制可提供细菌的多重耐药性,但是对抗生素的特异性较差。多项研究已证实沙门菌膜孔蛋白和抗生素的耐药存在密切联系。
细菌对抗菌药物的酶解作用
长期处于抗生素环境中的沙门菌会产生各种水解该类抗生素的酶。例如,在临床分离沙门菌中,其产生的β-内酰胺酶可水解β-内酰胺环使β-内酰胺类抗生素失去活性,是细菌对β-内酰胺类抗生素耐药的主要机制。
改变药物作用的靶位点
沙门菌可在抗生素压力下,通过改变抗菌药物结合位点或使得药物作用的靶基因发生突变,使得靶基因表达产物的空间构型与理化性质发生变化,从而导致抗菌药物失效或活性减弱。经典的例子是DNA旋转酶(GyrA和GyrB)和拓扑异构酶Ⅳ(ParC和ParE)的编码基因发生突变,导致沙门菌对喹诺酮类药物耐药性。
可移动元件介导的耐药性
细菌中广泛存在可能含有耐药基因的可移动元件,如质粒、转座子、整合子等,它们可通过接合或转导作用在不同的细菌之间扩散,从而将多种耐药性传递给其他细菌。许多相关研究结果表明,细菌的耐药基因具有传递性,它们通过可移动元件介导进行耐药性的转移,这也是沙门菌产生耐药的重要机制。
传播机制
传染源
伤寒和副伤寒沙门氏菌:传染源为病人和带菌者,后者在沙门菌感染中的作用更为重要。约有1%~5%的伤寒或副伤寒病人,在症状消失后1年仍可在其粪便中检出有相应沙门菌,转变为无症状(健康)带菌者。无症状带菌也可能是感染后唯一的临床表现。这些细菌留在胆囊中,有时也可在尿道中,成为人类伤寒和副伤寒病原菌的储存场所和重要传染源。
非伤寒沙门菌:传染源主要为感染的家禽、家畜及鼠类和其他野生动物。人感染后带菌时间可长达数周,也可作为重要传染源,成为医院内感染的重要途径。
传播途径
伤寒沙门氏菌:通过粪-口途径感染人体,伤寒可通过污染的水或食物、日常生活接触、苍蝇与蟑螂等传递病原菌而传播。水源污染是本病传播的重要途径,也常常是伤寒暴发流行的主要原因。 食物受污染亦可引起本病流行。散发病例一般以日常生活接触传播为多。副伤寒沙门氏菌传播途径基本与伤寒沙门氏菌相同。

非伤寒沙门菌:污染的食物、水源、污染用具接触传播。进食污染的肉、蛋、奶、鱼类,及其加工产品(包括动物原料制成的药物等)和植物性食品等均可患病。昆虫媒介如苍蝇和蟑螂等也可机械携带传播。
感染机制
易感与高危群体
人对本病普遍易感,婴幼儿、免疫功能低下者和严重慢性病患者易感。
潜伏期
沙门氏菌引起的肠热症潜伏期为7~20天,沙门氏菌引起的败血症潜伏期不定,沙门氏菌引起的胃肠炎潜伏期为8~48小时。
临床表现
无症状(健康)带菌者
约有1%~5%的伤寒或副伤寒病人,在症状消失后1年仍可在其粪便中检出有相应沙门氏菌,转变为无症状(健康)带菌者。无症状带菌也可能是感染后唯一的临床表现。年龄和性别与无症状带菌关系密切。20岁以下,无症状带菌率常小于1%,而50岁以上者,可达10%以上。女性转变为无症状带菌状态是男性的2倍。其他沙门氏菌感染,50%病人在5周内停止排菌,90%在感染后9周培养阴性,转变为无症状带菌者很少,不到1%。
肠热症
包括伤寒沙门菌引起的伤寒,以及甲型副伤寒沙门菌、肖氏沙门菌(原称乙型副伤寒沙门菌)、希氏沙门菌引起的副伤寒。伤寒和副伤寒的致病机制和临床症状基本相似,只是副伤寒的病情较轻,病程较短。
病人出现发热、不适、全身疼痛等前驱症状,体温先呈阶梯式上升,持续1周,然后高热(39~40℃)保持7~10天,同时出现缓脉,肝脾大,全身中毒症状显著,皮肤出现玫瑰疹,外周白细胞明显下降。胆囊中的细菌随胆汁进人肠道,一部分随粪便排出体外,另一部分再次侵入肠壁淋巴组织,使已致敏的组织发生超敏反应,导致局部坏死和溃疡,严重者有出血或肠穿孔等并发症。以上病变在疾病的第2~3周出现,若无并发症,自3~4周后病情开始好转。在5%~10%未经治疗的病人,可出现复发。但与初始疾病相比,病程一般较短,病情较轻,但也有严重病例,甚至死亡者。未经治疗的典型伤寒病人死亡率约为20%。
胃肠炎
胃肠炎是最常见的沙门菌感染,约占70%,由摄入大量被鼠伤寒沙门菌、猪霍乱沙门菌、肠炎沙门菌等污染食品引起,起病急,主要临床症状为发热、恶寒、呕吐、腹痛、水样腹泻,偶有黏液或脓性腹泻。严重者可伴有迅速脱水,导致休克、肾衰竭而死亡。死亡率可达2%,多见于老人、婴儿和体弱者。一般沙门菌胃肠炎多在2~3天自愈。
败血症
病菌以猪霍乱沙门菌、希氏沙门菌、鼠伤寒沙门菌、肠炎沙门菌等常见。病人多见于儿童和免疫力低下的成人。经口感染后,病菌早期即进入血液循环。败血症症状严重,有高热、寒战、厌食和贫血等,但肠道症状较少见。在10%的病人,因细菌的血流播散,可出现局部化脓性感染,如脑膜炎、骨髓炎、胆囊炎、心内膜炎、关节炎等。
诊断检查
诊断与鉴别诊断
诊断依据
主要根据临床特征与实验室检查结果,流行病学资料亦有参考价值。
流行病学资料:有不洁饮食史、既往病史、预防接种史以及曾与患者接触史。
临床表现:持续发热1周以上,表情淡漠、呆滞、腹胀、便秘或腹泻,相对缓脉,玫瑰疹、脾肿大等。并发肠出血或肠穿孔则有助诊断。对不典型的轻症患者亦应注意,以免误诊、漏诊。
实验室检查:外周血白细胞总数减少,淋巴细胞相对增多,嗜酸性粒细胞计数减少或消失。肥达试验阳性有辅助诊断意义。确诊的依据是检出伤寒沙门菌。早期以血培养为主,后期则可考虑作骨髓液培养。血培养阴性者,进行骨髓液培养有助于提髙阳性率。粪便培养对确定排菌状态很有帮助。
鉴别诊断
病毒性上呼吸道感染:患者有髙热、头痛、白细胞减少等表现与伤寒相似。但起病急,咽痛、鼻塞、咳嗽等呼吸道症状明显,没有表情淡漠、玫瑰疹、肝脾肿大,肥达试验与血培养均阴性。病程一般在1~2周以内。
疟疾:患者有发热、肝脾肿大、白细胞减少与伤寒相似。可借助患者发热前常有畏寒与寒战,热退时大汗,体温波动大,退热后一般情况好,红细胞和血红蛋白降低,外周血或骨髓涂片可找到疟原虫等临床特点与伤寒相鉴别。伤寒与恶性疟的鉴别诊断较为困难尤其应予重视。
钩端螺旋体病:近期有疫水接触史。起病急,伴畏寒发热,眼结膜充血,急性热性病容易于伤寒淡漠面容区别。钩体病特殊的全身酸痛,腓肠肌痛与压痛,腹股沟淋巴结肿痛表现也是伤寒罕有的。部分病例有黄疽与出血征象。尿少甚至无尿,尿中有蛋白质,红、白细胞与管型。白细胞数上升与核左移,血沉加速。血清凝集溶价试验阳性。
流行性斑疹伤寒:有虱咬史,多见于冬春季。急起高热、寒战、脉快,结膜充血,神经系统症状出现早,皮疹常在病程3-5天出现,量多,分布广,色暗红,压之不褪色。白细胞多为正常,外斐反应(Weil-Felix反应)阳性。病程一般2周左右。地方性斑疹伤寒则以8~9月多见,有鼠蚤叮咬史,病情较轻,病程较短,外斐反应OX19亦呈阳性,临床表现相似。
血行播散性结核病:患者有长期发热、白细胞降低与伤寒相似。可借助患者常有结核病史或结核患者接触史,发热不规则、伴有盗汗,结核菌素试验阳性,X线胸部照片可见粟粒性结核病灶等临床特点,以及抗结核病治疗有效与伤寒相鉴别。
革兰阴性杆菌败血症:起病急,发热伴全身中毒表现,常伴有寒战、多汗。可早期出现休克,持续较长时间。白细胞总数亦可正常或稍有下降,常伴核左移。可发现有胆道、尿路或肠道等处的原发感染灶。常需血培养发现致病菌确诊。
恶性组织细胞病:不规则高热,进行性贫血、出血、淋巴结肿大、脾肿大,病情进展较快,病程可达数月。外周血常规全血细胞减少,骨髓的细胞学检查可发现恶性组织细胞。
微生物学检查法
标本
肠热症随病程的进展,细菌出现的主要部位不同,因而应根据不同的病程采取不同标本。第1周取外周血,第2周起取粪便,第3周起还可取尿液,从第1周至第3周均可取骨髓液。副伤寒病程较短,因此采样时间可相对提前。胃肠炎取粪便和可疑食物。败血症取血液。胆道带菌者可取十二指肠引流液。
分离培养和鉴定
血液和骨髓液需要增菌,然后再划种于肠道选择鉴别培养基;粪便和经离心的尿沉淀物等直接接种于SS选择鉴别培养基或者其他肠道鉴别培养基。37℃孵育24小时后,挑取无色半透明的乳糖不发酵菌落接种至双糖或三糖铁培养基。若疑为沙门菌,再继续做系列生化反应,并用沙门菌多价抗血清做玻片凝集试验予以确定。
有学者采用SPA协同凝集试验、对流免疫电泳、乳胶凝集试验和ELISA法等,来快速早期诊断粪便、血清或尿液中的沙门菌等可溶性抗原。PCR法等分子生物学技术也可用于沙门菌感染的快速诊断。
在流行病学调查和传染源追踪中,Vi噬菌体分型也是一种常用方法。标准Vi噬菌体有33个型,其特异性比血清学分型更为专一。
血清学诊断
肠热症病程长,因抗生素使用普遍,肠热症的症状常不典型,临床标本阳性分离率低,故血清学试验仍有协助诊断的意义。用于肠热症的血清学试验有肥达试验(Widaltest)、间接血凝法、EIA法等,其中肥达试验仍较普及。
肥达试验是用已知伤寒沙门菌菌体O抗原和鞭毛H抗原,以及引起副伤寒的甲型副伤寒沙门菌、肖氏沙门菌和希氏沙门菌鞭毛H抗原的诊断菌液与受检血清做试管或微孔板定量凝集试验,测定受检血清中有无相应抗体及其效价的试验。
肥达试验结果的解释必须结合临床表现、病程、病史以及地区流行病学情况。
1.正常值:人们因沙门菌隐形感染或预防接种,血清中含有一定量的有关抗体,且其效价随地区而有差异。一般是伤寒沙门菌O凝集效价小于1:80,H凝集效价小于1:160,引起副伤寒的沙门菌H凝集效价小于1:80。只有当检测结果等于或大于上述相应数值时才有诊断价值。
2.动态观察:有时单次效价测定不能定论,可在病程中逐周复查。若效价逐次递增或恢复期效价比初次效价>4倍者即有诊断意义。
3.O与H抗体的诊断意义:患伤寒或副伤寒后,O与H在体内的消长情况不同。IgM类O抗体出现较早,持续约半年,消退后不易受非伤寒沙门菌等病原体的非特异刺激而重现。IgG类H抗体则出现较晚,持续时间长达数年,消失后易非特异性病原刺激而能短暂地重新出现。因此,O、H凝集效价均超过正常值,则肠热症的可能性大;如两者均低,病人可能性小;若O不高H高,有可能是预防接种或非特异性回忆反应;如O高H不高,则可能是感染早期或与伤寒沙门菌O抗原有交叉反应的其他沙门菌(如肠炎沙门菌)感染。
4.其他:有少数病例,在整个病程中,肥达试验始终在正常范围内。其原因可能由于早期使用抗生素治疗,或病人免疫功能低下等所致。
伤寒带菌者的检出
最可靠的诊断方法是分离出病原菌。分离标本来自可疑带菌者的粪便、胆汁或尿液,但通常分离检出率不高。因此,一般先用血清学方法检测可疑者Vi抗体进行筛选,若效价≥1:10时,再反复取粪便等进行分离培养,以确定是否为伤寒带菌者。
干预治疗
一般治疗
消毒和隔离
患者入院以后应按照肠道传染病常规进行消毒隔离。
休息
发热期患者应卧床休息,退热后2~3天可在床上稍坐,退热后1周才由轻度活动逐渐过渡至正常活动量。
护理
观察体温、脉搏、血压和粪便性状等变化。注意口腔和皮肤清洁,定期更换体位,预防压疮和肺部感染。
饮食
发热期应给予流质或无渣半流饮食,少量多餐。退热后饮食仍应从稀粥、软质饮食逐渐过渡,退热后2周才能恢复正常饮食。饮食的质量应包括足量的碳水化合物、蛋白质和各种维生素,以补充发热期的消耗,促进恢复。过早进食多渣、坚硬或容易产气的食物有诱发肠出血和肠穿孔的危险。
对症治疗
降温措施
高热时可进行物理降温,使用冰袋冷敷和(或)25%~30%乙醇四肢擦浴。发汗退热药,如阿司匹林有时可引起低血压,以慎用为宜。
便秘
可使用生理盐水300~500ml低压灌肠。无效时可改用50%甘油60ml或液体石蜡100ml灌肠。禁用高压灌肠和泻剂。
腹胀
饮食应减少豆奶、牛奶等容易产气的食物。腹部使用松节油涂擦,或者肛管排气。禁用新斯的明等促进肠蠕动的药物。
腹泻
应选择低糖低脂肪的食物。酌情给予小檗碱(黄连素)0.3g,口服,每天3次,一般不使用鸦片制剂,以免引起肠蠕动减弱,产生腹中积气。
肾上腺皮质激素
仅适用于出现谵妄、昏迷或休克等严重毒血症状的高危患者,应在有效足量的抗菌药物配合下使用,可降低病死率。可选择地塞米松5000mg静脉滴注,每天1次。或者氢化可的松50~100mg静脉滴注,每天1次。疗程一般3天。使用肾上腺皮质激素有可能掩盖肠穿孔的症状和体征,在观察病情变化时应给予重视。
病原治疗
自1948年以来,氯霉素治疗伤寒已有50余年的历史,曾被作为治疗伤寒的首选药物。20世纪50年代已发现耐氯霉素的伤寒菌株;有些伤寒菌株则呈现多重耐药性。因此,氯霉素、氨苄西林和复方磺胺甲嗯唑仅用于敏感菌株的治疗。20世纪90年代后,国内外许多报道推荐第三代喹诺酮类药物为治疗伤寒的首选药物。但随着第三代喹诺酮类药物的广泛应用,已报道伤寒菌株对第三代喹诺酮类药物出现耐药。第三代头孢菌素的抗菌活性强,在治疗氯霉素敏感的伤寒菌株、氯霉素耐药的伤寒菌株以及多重耐药的伤寒菌株中都能获得满意的疗效。
因此,在没有药物敏感性试验结果之前,伤寒经验治疗的首选药物仍推荐使用第三代喹诺酮类药物,儿童和孕妇伤寒患者宜首先应用第三代头孢菌素。治疗开始以后,必须密切观察疗效,尽快取得药物敏感性试验的结果,以便决定是否需要进行治疗方案的调整。
带菌者的治疗
根据药敏试验选择治疗药物,一般可选择:氧氟沙星、左氧氟沙星或环丙沙星。氧氟沙星,每次0.2g,口服,每天2次;左氧氟沙星每次0.5g,每天1次;或者环丙沙星,每次0.5g,口服,每天2次,疗程4~6天。
预防免疫
管理传染源
患者应按肠道传染病隔离。体温正常后的第15天才解除隔离。如果有条件,症状消失后5天和10天各做尿、粪便培养,连续2次阴性,才能解除隔离。慢性携带者应调离饮食业,并给予治疗。接触者医学观察15天。
切断传播途径
应做好水源管理、饮食管理、粪便管理和消灭苍蝇等卫生工作。要避免饮用生水,避免进食未煮熟的肉类食品,进食水果前应洗净或削皮。
保护易感人群
对易感人群进行伤寒、副伤寒甲、乙三联菌苗预防接种,皮下注射3次,间隔7-10天,各0.5ml、1.0ml、1.0ml;免疫期为1年。每年可加强1次,1.0ml,皮下注射。伤寒Ty21a活疫苗,第1、3、5和7天各口服1个胶囊。以上疫苗仅有部分免疫保护作用。因此,已经进行免疫预防的个体,仍然需要注意饮食卫生。
流行病学
沙门氏菌是普遍且发病率较高的食源性细菌,该菌可以通过多种途径传播,因此沙门氏菌感染成为了全球公共卫生、动物和食品工业的一个主要问题。2021年,美国食品药品监督管理局(FDA)公布全球每年有1.53亿次由沙门氏菌引起的流行病爆发,91.28%是通过食物传播的,8.72%是由未知原因引起的。
非洲大陆:从1984年到2006年,非洲肠炎沙门氏菌累计流行率在各地区差异明显,如在北非(49.9%)、东非(12%)、南非(3%)以及西非和中非(13%),在众多引起沙门氏菌感染的食物中,沙拉和三明治占比为25%、新鲜水果和蔬菜占比为5.8%、肉制品、乳制品、鸡蛋和海鲜占比为69.2%。
欧洲:2017年,欧洲食品安全局(EFSA)和欧洲疾病预防控制中心(ECDC)报告了奥地利、比利时、保加利亚等28个国家在2012年至2016年的沙门氏菌感染病例分别为94278人、87753人、92012人、94597人和94530人。
中国:2021年伤寒和副伤寒疫情报告发病7244人,死亡0人;2020年伤寒和副伤寒报告发病7011人,死亡5人;2019年伤寒和副伤寒报告发病9274人,死亡0人;2018年伤寒和副伤寒报告发病10843人,死亡2人;2017年伤寒和副伤寒报告发病10791人,死亡3人;2016年伤寒和副伤寒报告发病10899人,死亡1人。
相关研究
重组减毒沙门氏菌载体
细菌介导的肿瘤治疗已成为肿瘤研究领域的热点之一,这种治疗手段主要依赖于细菌的肿瘤定植能力和靶向特点,通过自身的溶瘤机制及刺激机体产生免疫反应对肿瘤进行抑制和消除。避免了化疗药物不完全渗透和耐药性的产生。沙门氏菌具有肿瘤特异性高、组织渗透性深、易于基因修饰、安全性好等优点,作为抑制肿瘤生长和转移的治疗载体而被广泛应用。减毒沙门氏菌载体的递送系统不仅克服了渗透限制,实现了疫苗抗原及药物的特异性释放,还能与其他疗法如光热疗法联合治疗,具有极强的应用潜能。